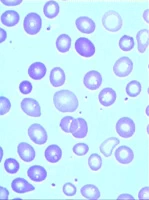

Anisocytosis คือเม็ดเลือดแดงขนาดไม่เท่ากัน
ในคนปกติ เม็ดเลือดแดง (Red Blood Cells หรือ RBCs) จะมีขนาดใกล้เคียงกัน แต่ **Anisocytosis** คือ ภาวะที่เม็ดเลือดแดงมีขนาดไม่เท่ากัน อาจมีขนาดเล็กกว่าปกติ (Microcytosis) ใหญ่กว่าปกติ (Macrocytosis) หรือมีทั้งสองขนาดคละเคล้ากันไปในแต่ละ field ที่ส่องกล้อง ภาวะนี้ไม่พบในคนปกติ และมักบ่งบอกถึงความผิดปกติ เช่น ภาวะโลหิตจาง, การขาดสารอาหาร, หรือโรคเรื้อรัง
ภาพสเมียร์เลือดแสดงเม็ดเลือดแดงขนาดไม่เท่ากันในภาวะ Anisocytosis
เพื่อยืนยันภาวะนี้ แพทย์มักใช้การตรวจ **Red Blood Cell Distribution Width (RDW)** ซึ่งเป็นการวินิจฉัยการกระจายตัวของขนาดเม็ดเลือดแดง ค่าปกติของ RDW อยู่ที่ 11.5 – 14.5% หากค่า RDW สูงกว่าปกติ แปลว่ามีเม็ดเลือดแดงขนาดไม่เท่ากันมากกว่าปกติ ซึ่งบ่งบอกถึงภาวะ Anisocytosis
การแบ่งชนิดของ Anisocytosis
การแบ่งชนิดของ Anisocytosis มักใช้ค่า Mean Corpuscular Volume (MCV) ซึ่งบ่งบอกขนาดเฉลี่ยของเม็ดเลือดแดง โดยสามารถแบ่งได้ดังนี้:
อาการของ Anisocytosis
อาการของ Anisocytosis มักขึ้นอยู่กับสาเหตุที่ทำให้เกิดภาวะนี้ ซึ่งส่วนใหญ่เกี่ยวข้องกับภาวะโลหิตจาง โดยมีอาการหลัก ดังนี้:
อาการเหล่านี้เกิดจากการที่เม็ดเลือดแดงไม่สามารถนำออกซิเจนไปเลี้ยงเนื้อเยื่อและอวัยวะของร่างกายได้อย่างเพียงพอ ซึ่งมักเป็นผลจากขนาดเม็ดเลือดแดงที่ผิดปกติ
สาเหตุของ Anisocytosis
Anisocytosis มักเป็นอาการของความผิดปกติอื่น ๆ โดยเฉพาะภาวะโลหิตจาง ซึ่งอาจเกิดจากสาเหตุดังต่อไปนี้:
นอกจากนี้ ภาวะ Anisocytosis อาจพบในผู้ที่มีโรคหัวใจและหลอดเลือด หรือมะเร็งบางชนิด
การวินิจฉัย Anisocytosis
แพทย์มักวินิจฉัย Anisocytosis ผ่านการตรวจความสมบูรณ์ของเม็ดเลือด (CBC) ซึ่งรวมถึงการวัดค่า RDW เพื่อดูการกระจายตัวของขนาดเม็ดเลือดแดง หากพบความผิดปกติ แพทย์อาจทำการตรวจเพิ่มเติมเพื่อหาสาเหตุ เช่น:
แพทย์อาจซักประวัติเพิ่มเติม เช่น ประวัติครอบครัวเกี่ยวกับโรคโลหิตจาง, อาการอื่น ๆ, การรับประทานยา, หรือพฤติกรรมการรับประทานอาหาร เพื่อหาสาเหตุที่แท้จริง
วิธีการรักษา Anisocytosis
การรักษา Anisocytosis ขึ้นอยู่กับสาเหตุที่ทำให้เกิดภาวะนี้ ดังนี้:
การรักษาควรอยู่ภายใต้การดูแลของแพทย์ เพื่อให้แน่ใจว่าปลอดภัยและเหมาะสมกับสภาพของผู้ป่วย
Anisocytosis ในการตั้งครรภ์
ในหญิงตั้งครรภ์ Anisocytosis มักเกิดจากภาวะโลหิตจางจากการขาดธาตุเหล็ก เนื่องจากร่างกายต้องการธาตุเหล็กมากขึ้นเพื่อสร้างเม็ดเลือดแดงให้เพียงพอสำหรับทั้งแม่และทารกในครรภ์ การตรวจ RDW สามารถช่วยตรวจพบการขาดธาตุเหล็กในระยะเริ่มต้นได้
หากไม่รักษา ภาวะโลหิตจางในระหว่างตั้งครรภ์อาจส่งผลกระทบ ดังนี้:
หากสงสัยว่ามี Anisocytosis ระหว่างตั้งครรภ์ แพทย์อาจแนะนำให้ตรวจเพิ่มเติมและเริ่มการรักษาทันที เช่น การเสริมธาตุเหล็กหรือวิตามิน
ภาวะแทรกซ้อนของ Anisocytosis
หากไม่ได้รับการรักษา Anisocytosis หรือสาเหตุที่แท้จริงอาจนำไปสู่ภาวะแทรกซ้อน ดังนี้:
สรุป
Anisocytosis คือ ภาวะที่เม็ดเลือดแดงมีขนาดไม่เท่ากัน ซึ่งมักเป็นสัญญาณของความผิดปกติ เช่น ภาวะโลหิตจาง, การขาดสารอาหาร, หรือโรคเรื้อรัง การรักษาจะขึ้นอยู่กับสาเหตุ เช่น การเสริมวิตามิน, การถ่ายเลือด หรือการรักษาโรคหลัก แนวโน้มระยะยาวขึ้นอยู่กับการรักษาที่รวดเร็วและเหมาะสม หากเกิดจากภาวะขาดสารอาหาร มักรักษาได้เป็นง่าย แต่หากเกิดจากโรคทางพันธุกรรม เช่น โรคธาลัสซีเมีย อาจต้องดูแลตลอดชีวิต
สำหรับหญิงตั้งครรภ์ ควรให้ความสำคัญกับภาวะนี้เป็นพิเศษ เนื่องจากอาจส่งผลกระทบต่อทั้งมารดาและทารกในครรภ์ หากมีอาการ เช่น อ่อนเพลีย, ผิวซีด หรือหายใจลำบาก ควรรีบปรึกษาแพทย์เพื่อตรวจวินิจฉัยและรับการรักษาที่เหมาะสม
อ่านเพิ่มเติม
Hemoglobin | Hematocrit | Red Blood Cell | Inclusion Body | เม็ดเลือดแดง | Reticulocyte Count | MCV | MCHC | MCH | ลักษณะเม็ดเลือดแดง | เกล็ดเลือด | เม็ดเลือดขาว | Neutrophil | Lymphocyte | Eosinophil | Monocyte | Basophil | Rh | กรุปเลือด
วันที่ 21/1/2566 (ปรับปรุงล่าสุด: 26/4/2568)
โดย นายแพทย์ ประพันธ์ ปลื้มภาณุภัทร อายุรแพทย์, แพทย์เวชศาสตร์ครอบครัว


